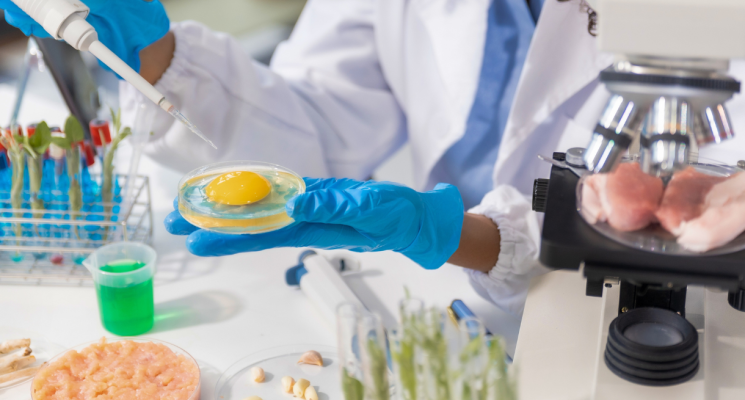

UTI ou emergência: qual área da enfermagem tem mais vagas, paga melhor e oferece mais oportunidades? »
Quem está construindo carreira na enfermagem já deve ter se feito essa pergunta pelo menos uma vez: UTI ou emergência?
Embora as duas
Como é trabalhar em UTI? O que ninguém te conta sobre desafios e habilidades »
Como é trabalhar em UTI? Para quem observa de fora, a resposta costuma parecer simples: monitorar pacientes graves, administrar medicamentos e agir rapidamente
Pós-Graduação em Enfermagem Cardiovascular: vale a pena? »
Logo cedo, a rotina em uma unidade coronariana já começou. Monitores cardíacos emitem alertas constantes, pacientes recém-saídos de procedimentos precisam de observação contínua
Entenda a importância dos cuidados paliativos no tratamento humanizado »
Em muitos hospitais, o cenário se repete diariamente: pacientes com doenças crônicas avançadas passam por múltiplas internações, procedimentos invasivos e longos protocolos clínicos
Perder pacientes: o erro silencioso que afasta consultas »
Existe um momento que muitos profissionais de saúde conhecem, mas poucos conseguem explicar com clareza. A agenda começa a mudar, os retornos diminuem,
Como migrar para a ciência de dados na saúde mesmo sem formação em tecnologia »
A transformação digital chegou de vez à saúde. Hospitais, clínicas, operadoras e laboratórios passaram a lidar diariamente com um volume gigantesco de informações:
Como fazer a gestão de segurança do paciente na saúde »
Um paciente chega ao pronto atendimento com dor abdominal intensa, passa por triagem, medicação, exames, encaminhamento, internação, cirurgia e recuperação.
Em cada etapa,
Vale a pena se especializar em dor ortopédica? Veja oportunidades »
Tem profissionais da saúde que passam anos atendendo pacientes com dores musculoesqueléticas sem conseguir atuar de forma realmente diferenciada. Outros escolhem aprofundar conhecimentos,
Vale a pena se especializar em dor oncológica? »
Existe uma pergunta que tem aparecido cada vez mais entre médicos, residentes e profissionais de saúde que buscam um caminho sólido: vale a
Educação Física Hospitalar: o futuro da profissão vai muito além da academia »
Durante muito tempo, quando alguém dizia “vou fazer Educação Física”, a resposta vinha quase automática: “Ah, vai ser personal?” ou “Vai trabalhar em
ADS ou Sistemas de Informação: qual curso de tecnologia escolher? »
A escolha de um curso de tecnologia costuma começar com uma pergunta simples: “Eu gosto de computador?”. Mas, quando a gente olha mais
Análise e Desenvolvimento de Software na Saúde: por que a Faculdade Santa Casa é o futuro »
Em um cenário de transformações aceleradas, muitos ainda associam oportunidades em tecnologia apenas ao universo de fintechs e plataformas de consumo.
No entanto,
Dia do Enfermeiro: o protagonismo da enfermagem na saúde do futuro »
Como a profissão está se transformando com tecnologia, humanização e novas demandas do mercado
Pós-graduação em Farmácia: carreiras e mercado além do balcão »
Durante muito tempo, a Farmácia foi enxergada por um único ângulo: o balcão, a receita, a orientação ao paciente e a rotina da
Pós-graduação em Gestão em Saúde: cursos, mercado e oportunidades para liderar o setor »
Em um hospital, nem tudo acontece dentro de um centro cirúrgico.
Enquanto médicos salvam vidas, existe uma engrenagem silenciosa que garante que tudo
Pós-graduação presencial em Odontologia: primeiro passo para avançar na carreira clínica »
Logo após a graduação, muitos profissionais se deparam com uma sensação recorrente: apesar da formação concluída, ainda existe uma distância entre o conhecimento
Liderança neurocompatível: como gerir pessoas respeitando o funcionamento do cérebro »
Nos últimos anos, falar sobre liderança deixou de significar apenas metas, resultados e produtividade. Hoje, gestores precisam compreender um fator essencial:
Especialização em Saúde Coletiva: por que investir nessa formação agora »
A saúde coletiva nunca foi tão estratégica quanto nos últimos anos. Em um cenário marcado por desigualdades sociais, crises sanitárias e transformações
Especialização em saúde mental e demandas do mercado de trabalho »
A saúde mental tornou-se um dos principais desafios da sociedade contemporânea. Nas últimas décadas, mudanças no estilo de vida, no mundo do trabalho
Especialização em fonoaudiologia: por que o mercado exige profissionais cada vez mais capacitados »
A área da saúde passa por transformações constantes impulsionadas pelo avanço científico, pelas mudanças no perfil da população e pelo aumento da demanda
Especialização em Fisioterapia e atuação em saúde »
A fisioterapia deixou de ser vista apenas como etapa final da reabilitação. Hoje, ela ocupa posição estratégica dentro de hospitais, UTIs, centros esportivos,
Especialização para profissional de enfermagem: caminhos para a carreira na FCMSCSP »
Na vida de um profissional de enfermagem, existem momentos decisivos: o primeiro plantão, o cuidado que transforma uma noite difícil, a escolha de
Tendências da área da saúde e o papel da Pós-Graduação »
A área da saúde passa por transformações constantes impulsionadas por avanços tecnológicos, mudanças demográficas e novas demandas assistenciais. Diante desse cenário, é preciso
Dia do Esportista destaca a importância da formação em Educação Física »
Celebrado em 19 de fevereiro, o Dia do Esportista vai além da homenagem a atletas e profissionais da área. A data chama atenção para
Conheça o Programa Expedições Científicas e Assistenciais (PECA) »
O Programa Expedições Científicas e Assistenciais (PECA) é um projeto de extensão universitária da Faculdade de
5 motivos para fazer uma Pós-Graduação Lato Sensu »
Está com dúvidas sobre qual caminho seguir para ter uma carreira de excelência nas áreas da saúde ou da tecnologia? Separamos 5 dos
Conheça o Conecta Santa: conectando você às oportunidades de carreira »
A Faculdade de Ciências Médicas da Santa Casa de São Paulo (FCMSCSP) lançou o Conecta Santa, uma plataforma pensada para aproximar você
A Importância da Administração Hospitalar para a Qualidade da Saúde »
O curso de Administração Hospitalar visa implementar mudanças nos processos administrativos das organizações de saúde, pois a forma
Medicina Aeroespacial: como a exploração espacial transforma a saúde humana na Terra »
A Medicina Aeroespacial pode parecer um tema distante da rotina da maioria das pessoas. No entanto, essa área está na linha de
Inscrições abertas para as turmas de 2026 da Pós-Graduação em Infertilidade Conjugal e Reprodução Humana »
Se você é um médico especializado ou não nas áreas de Ginecologia e Urologia, conheça a Pós-Graduação em Infertilidade Conjugal e Reprodução
Pós-Graduação em Administração Hospitalar forma líderes na gestão da saúde »
A Pós em Administração Hospitalar na Faculdade Santa Casa de SP prepara profissionais para atuarem de forma estratégica na gestão
Viva um dia imersivo na saúde: vem aí o Santa Day! »
Se você está pensando em seguir carreira na área da saúde, a oportunidade perfeita para dar o primeiro passo já tem datas marcadas.
Perguntas Frequentes da Pós-Graduação Lato Sensu da Faculdade Santa Casa SP »
A Pós-Graduação Lato Sensu da Faculdade de Ciências Médicas da Santa Casa de São Paulo (FCMSCSP) oferece especializações
Faculdade Santa Casa lança curso de tecnologia focado em soluções para a saúde »
Depois da pandemia da Covid-19, a relação entre tecnologia e serviços de saúde cresceu de forma exponencial. De acordo com a
Mercado de nutrição esportiva: crescimento no Brasil e novas oportunidades de carreira »
O mercado de nutrição esportiva tem apresentado forte expansão no Brasil. De acordo com projeções da Associação Brasileira
Curso de Farmácia da Faculdade Santa Casa de SP: Inscrições Abertas para 2026 »
Se você busca uma formação sólida e inovadora na área da saúde, o curso de graduação em Farmácia
Curso de Tecnologia em Sistemas Biomédicos da FCMSCSP: Sua carreira tecnológica na saúde começa aqui »
Se você deseja uma formação que una tecnologia, saúde e inovação, o curso de Tecnologia em Sistemas Biomédicos
Curso de Tecnologia em Radiologia da FCMSCSP: Formação Prática e Inovadora para o Mercado de Saúde »
Se você busca uma carreira dinâmica e com alta empregabilidade no setor da saúde, então o curso de Tecnologia em
Soft e Hard Skills: Como a Pós-Graduação Impulsiona sua Carreira »
De acordo com o relatório de junho de 2025 do TestGorilla, plataforma on-line especializada em contratação de profissionais, 60% dos empregadores afirmam
Curso de Nutrição da FCMSCSP: Formação Completa para o Profissional do Futuro »
Se você busca uma carreira sólida e transformadora na área da saúde, o curso de Nutrição da Faculdade
Entenda como é o Bacharelado em Educação Física da Faculdade Santa Casa »
O Bacharelado em Educação Física da Faculdade Santa Casa é uma graduação completa voltada para formar profissionais preparados para atuar em saúde, esporte
Curso de Odontologia da Faculdade Santa Casa de SP: Excelência no ensino e formação profissional »
A Faculdade de Ciências Médicas da Santa Casa de São Paulo (FCMSCSP) é reconhecida por sua excelência na formação de profissionais
Curso de Educação Física da Faculdade Santa Casa de SP: foco em saúde integral e bem-estar »
O Brasil lidera os índices mundiais de ansiedade, segundo a Organização Mundial da Saúde (OMS). Para enfrentar esse cenário, a
Curso de Análise e Desenvolvimento de Sistemas: tecnologia e inovação na FCMSCSP »
Você já conhece o curso de Análise e Desenvolvimento de Sistemas da Faculdade Santa Casa de SP? Dessa forma, você
Por que fazer uma especialização? Descubra os benefícios para sua carreira »
Descubra por que fazer uma especialização pode transformar sua carreira e abrir novas oportunidades profissionais. Conheça os cursos de pós-graduação da
Conheça os cursos em parceria com a Infinity Doctors Education »
A Faculdade de Ciências Médicas da Santa Casa de São Paulo (FCMSCSP), em parceria com a Infinity Doctors